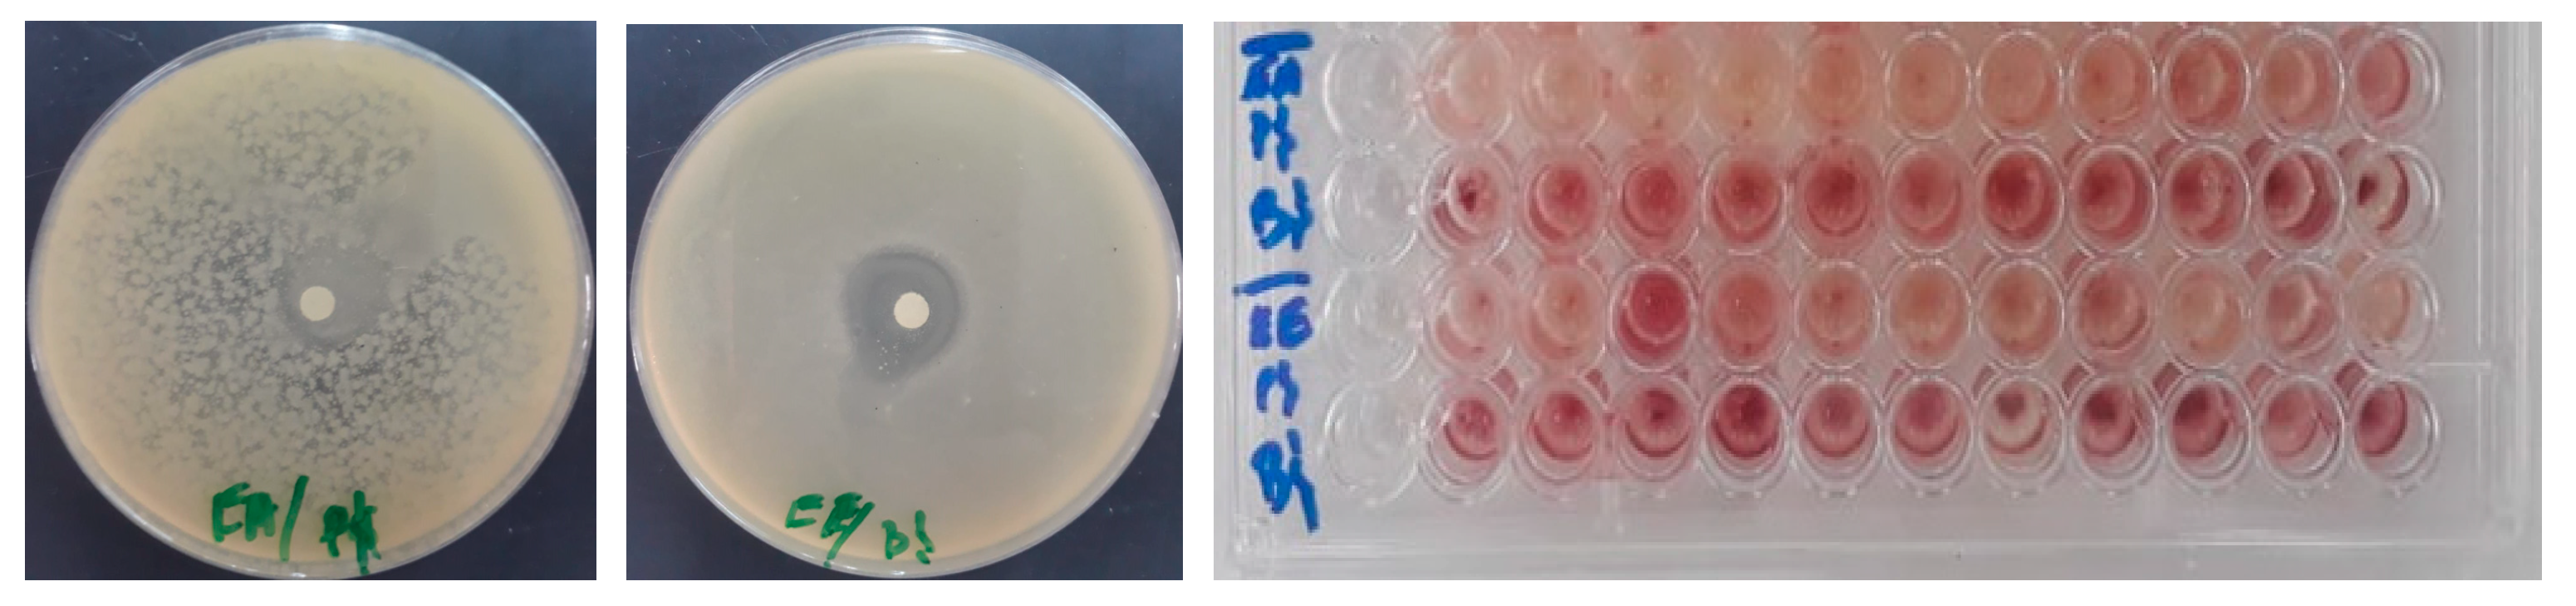
Life 13 00776 g004 Life 13 00776 g004

Extracts of Brocchia cinerea (Delile) Vis Exhibit In Vivo Wound Healing, Anti-Inflammatory and Analgesic Activities, and Other In Vitro Therapeutic Effects
Abstract
1. Introduction
2. Materiel and Methods
2.1. Preparation of BCAE and BCEE
2.2. Characterization of Phytochemicals
2.2.1. Quantification of Total Polyphenol Content (TPC)
2.2.2. Quantification of Total Flavonoids (Fl)
2.2.3. Quantification of Condensed Tannins (CT)
2.2.4. HPLC-DAD Analysis
Chemicals and Standard Preparations
HPLC-DAD Conditions
2.3. In Vitro Antioxidant Activity
2.3.1. Trapping of Free Radicals by 2,2′-Diphenyl 1-Picrylhydrazyl Radical (DPPH)
2.3.2. Ferric Reducing Antioxidant Power Assay (FRAP)
2.3.3. Quantification of Total Antioxidant Capacity (TAC)
2.4. Antibacterial Activity
2.4.1. Tested Strains
2.4.2. Disk Diffusion Method
2.4.3. Determination of the Minimum Inhibitory Concentration
2.5. Pharmacological Activities
2.5.1. Animal Handling and Housing
2.5.2. Wound Healing Test
Formulation of Ointment
Burn Wound Induction
2.5.3. Carrageenan-Induced Inflammation of the Right Rat Paw
2.5.4. Analgesic Activity
2.5.5. Statistical Analyses
3. Results and Discussion
3.1. TPC, Fl, CT and HPLC-DAD Analysis
3.2. Antioxidant Activity (TAC, DPPH and FRAP Tests)
3.3. Antibacterial Activity of BCAE and BCEE
3.4. Pharmacological Activities
3.4.1. Wound Healing Activity of B. cinerea Extracts
3.4.2. Anti-Inflammatory Activity
3.4.3. Peripheral Analgesic Activity
4. Conclusions
Author Contributions
Funding
Institutional Review Board Statement
Informed Consent Statement
Data Availability Statement
Acknowledgments
Conflicts of Interest
References
- Bouyahya, A.; Guaouguaou, F.E.; El Omari, N.; El Menyiy, N.; Balahbib, A.; El-Shazly, M.; Bakri, Y. Anti-Inflammatory and Analgesic Properties of Moroccan Medicinal Plants: Phytochemistry, in vitro and in vivo Investigations, Mechanism Insights, Clinical Evidences and Perspectives. J. Pharm. Anal. 2022, 12, 35–57. [Google Scholar] [CrossRef]
- Agour, A.; Mssillou, I.; Es-Safi, I.; Conte, R.; Mechchate, H.; Slighoua, M.; Amrati, F.E.; Parvez, M.K.; Numan, O.; Bari, A.; et al. The Antioxidant, Analgesic, Anti-Inflammatory, and Wound Healing Activities of Haplophyllum tuberculatum (Forsskal) A. Juss Aqueous and Ethanolic Extract. Life 2022, 12, 1553. [Google Scholar] [CrossRef] [PubMed]
- Allali, A.; Rezoukin, S.; Fadli, A.; El Moussaoui, A.; Bourhia, M.; Salamatullah, M.; Alzahrani, A.; Abdulhakeem, A.; Khalil Albadr, H.; Albadr, A.N.; et al. Chemical Characterization and Antioxidant, Antimicrobial, and Insecticidal Properties of Essential Oil from Mentha pulegium L. Evid.-Based Complement. Altern. Med. 2021, 2012, 1108133. [Google Scholar] [CrossRef]
- Rolnik, A.; Olas, B. The Plants of the Asteraceae Family as Agents in the Protection of Human Health. Int. J. Mol. Sci. 2021, 22, 3009. [Google Scholar] [CrossRef] [PubMed]
- Abazari, M.; Ghaffari, A.; Rashidzadeh, H.; Badeleh, S.M.; Maleki, Y. A Systematic Review on Classification, Identification, and Healing Process of Burn Wound Healing. Int. J. Low. Extrem. Wounds 2022, 21, 18–30. [Google Scholar] [CrossRef]
- Criollo-Mendoza, M.S.; Contreras-Angulo, L.A.; Leyva-López, N.; Gutiérrez-Grijalva, E.P.; Jiménez-Ortega, L.A.; Heredia, J.B. Wound Healing Properties of Natural Products: Mechanisms of Action. Molecules 2023, 28, 598. [Google Scholar] [CrossRef]
- Daou, A.; Baydoun, E.; Nasser, M.; Albahri, G.; Badran, A.; Hijazi, A. The Therapeutic Wound Healing Bioactivities of Various Medicinal Plants. Life 2023, 13, 317. [Google Scholar]
- Markiewicz-Gospodarek, A.; Kozioł, M.; Tobiasz, M.; Baj, J.; Radzikowska-Büchner, E.; Przekora, A. Burn Wound Healing: Clinical Complications, Medical Care, Treatment, and Dressing Types: The Current State of Knowledge for Clinical Practice. Int. J. Environ. Res. Public Health 2022, 19, 1338. [Google Scholar] [CrossRef]
- Wang, G.; Yang, F.; Zhou, W.; Xiao, N.; Luo, M.; Tang, Z. The Initiation of Oxidative Stress and Therapeutic Strategies in Wound Healing. Biomed. Pharmacother. 2023, 157, 114004. [Google Scholar] [CrossRef]
- Wu, Z.; Chen, L. Similarity-Based Method with Multiple-Feature Sampling for Predicting Drug Side Effects. Comput. Math. Methods Med. 2022, 2022, 9547317. [Google Scholar] [CrossRef]
- Miranda, G.M.; Ramos, E.; Santos, V.O.; Bessa, J.R.; Teles, Y.C.F.; Yahouédéhou, S.C.M.A.; Goncalves, M.S.; Ribeiro-Filho, J. Inclusion Complexes of Non-Steroidal Anti-Inflammatory Drugs with Cyclodextrins: A Systematic Review. Biomolecules 2021, 11, 361. [Google Scholar] [CrossRef] [PubMed]
- Komakech, R.; Matsabisa, M.G.; Kang, Y. The Wound Healing Potential of Aspilia Africana (Pers.) CD Adams (Asteraceae). Evid.-Based Complement. Altern. Med. 2019, 2019, 7957860. [Google Scholar] [CrossRef] [PubMed]
- Carvalho, A.R.; Diniz, R.M.; Suarez, M.A.M.; Figueiredo, C.S.S.S.; Zagmignan, A.; Grisotto, M.A.G.; Fernandes, E.S.; da Silva, L.C.N. Use of Some Asteraceae Plants for the Treatment of Wounds: From Ethnopharmacological Studies to Scientific Evidences. Front. Pharmacol. 2018, 9, 784. [Google Scholar] [CrossRef] [PubMed]
- Lambebo, M.K.; Kifle, Z.D.; Gurji, T.B.; Yesuf, J.S. Evaluation of Wound Healing Activity of Methanolic Crude Extract and Solvent Fractions of the Leaves of Vernonia auriculifera Hiern (Asteraceae) in Mice. J. Exp. Pharmacol. 2021, 13, 677–692. [Google Scholar] [CrossRef]
- Lakhdar, M. Traditional Uses, Phytochemistry and Biological Activities of Cotula cinerea Del: A Review. Trop. J. Pharm. Res. 2018, 17, 365–373. [Google Scholar] [CrossRef]
- Agour, A.; Mssillou, I.; Mechchate, H.; Es-Safi, I.; Allali, A.; El Barnossi, A.; Al Kamaly, O.; Alshawwa, S.Z.; El Moussaoui, A.; Bari, A.; et al. Brocchia cinerea (Delile) Vis. Essential Oil Antimicrobial Activity and Crop Protection against Cowpea Weevil Callosobruchus maculatus (Fab.). Plants 2022, 11, 583. [Google Scholar] [CrossRef]
- Markouk, M.; Bekkouche, K.; Larhsini, M.; Bousaid, M.; Lazrek, H.B.; Jana, M. Evaluation of Some Moroccan Medicinal Plant Extracts for Larvicidal Activity. J. Ethnopharmacol. 2000, 73, 293–297. [Google Scholar] [CrossRef]
- Cimmino, A.; Roscetto, E.; Masi, M.; Tuzi, A.; Radjai, I.; Gahdab, C.; Paolillo, R.; Guarino, A.; Catania, M.R.; Evidente, A. Sesquiterpene Lactones from Cotula cinerea with Antibiotic Activity against Clinical Isolates of Enterococcus Faecalis. Antibiotics 2021, 10, 819. [Google Scholar] [CrossRef]
- Bensizerara, D.; Menasria, T.; Melouka, M.; Cheriet, L.; Chenchouni, H. Antimicrobial Activity of Xerophytic Plant (Cotula cinerea Delile) Extracts Against Some Pathogenic Bacteria and Fungi. Jordan J. Biol. Sci. 2013, 6, 266–271. [Google Scholar] [CrossRef]
- Salhi, N.; Mohammed Saghir, S.A.; Terzi, V.; Brahmi, I.; Ghedairi, N.; Bissati, S. Antifungal Activity of Aqueous Extracts of Some Dominant Algerian Medicinal Plants. BioMed Res. Int. 2017, 2017, 7526291. [Google Scholar] [CrossRef]
- Chlif, N.; Bouymajane, A.; Oulad El Majdoub, Y.; Diouri, M.; Rhazi Filali, F.; Bentayeb, A.; Altemimi, A.B.; Mondello, L.; Cacciola, F. Phenolic Compounds, in vivo Anti-Inflammatory, Analgesic and Antipyretic Activities of the Aqueous Extracts from Fresh and Dry Aerial Parts of Brocchia cinerea (Vis.). J. Pharm. Biomed. Anal. 2022, 213, 114695. [Google Scholar] [CrossRef] [PubMed]
- Aydin, M.E.; Tekin, E.; Ahiskalioglu, E.O.; Ates, I.; Karagoz, S.; Aydin, O.F.; Ozkaya, F.; Ahiskalioglu, A. Erector Spinae Plane Block vs Non-Steroidal Anti-Inflammatory Drugs for Severe Renal Colic Pain: A Pilot Clinical Feasibility Study. Int. J. Clin. Pract. 2021, 75, e13789. [Google Scholar] [CrossRef] [PubMed]
- Mssillou, I.; Agour, A.; Slighoua, M.; Tourabi, M.; Nouioura, G.; Lyoussi, B.; Derwich, E. Phytochemical Characterization, Antioxidant Activity, and in vitro Investigation of Antimicrobial Potential of Dittrichia viscosa L. Leaf Extracts against Nosocomial Infections. Acta Ecol. Sin. 2021, 42, 661–669. [Google Scholar] [CrossRef]
- Boizot, N.; Charpentier, J.; Boizot, N.; Méthode, J.C. Méthode Rapide d’ Évaluation du Contenu en Composés Phénoliques Des Organes d’ Un Arbre Forestier to Cite This Version: HAL Id: Hal-02669118 Méthode Rapide d’ Évaluation du Contenu en Composés Phénoliques Des Organes d’ Un Arbre Forestier; INRA: Paris, France, 2020. [Google Scholar]
- Bahorun, T.; Gressier, B.; Trotin, F.; Brunet, C.; Dine, T.; Luyckx, M.; Vasseur, J.; Cazin, M.; Cazin, J.C.; Pinkas, M. Oxygen Species Scavenging Activity of Phenolic Extracts from Hawthorn Fresh Plant Organs and Pharmaceutical Preparations. Arzneimittelforschung 1996, 46, 1086–1089. [Google Scholar]
- Joslyn, M.A.; Glick, Z. Comparative Effects of Gallotannic Acid and Related Phenolics on the Growth of Rats. J. Nutr. 1969, 98, 119–126. [Google Scholar] [CrossRef]
- Mssillou, I.; Agour, A.; Slighoua, M.; Chebaibi, M.; Amrati, F.E.Z.; Alshawwa, S.Z.; Al Kamaly, O.; El Moussaoui, A.; Lyoussi, B.; Derwich, E. Ointment-Based Combination of Dittrichia viscosa L. and Marrubium vulgare L. Accelerate Burn Wound Healing. Pharmaceuticals 2022, 15, 289. [Google Scholar] [CrossRef]
- Sahin, F.; Gulluce, M.; Daferera, D.; Sokmen, A.; Sokmen, M.; Polissiou, M.; Agar, G.; Ozer, H. Biological Activities of the Essential Oils and Methanol Extract of Origanum vulgare ssp. Vulgare in the Eastern Anatolia Region of Turkey. Food Control 2004, 15, 549–557. [Google Scholar] [CrossRef]
- Oyaizy, M. Studies on Product of Browning Reaction Prepared from Glucose Amine. Jpn. J. Nutr. 1986, 44, 307–315. [Google Scholar] [CrossRef]
- Prieto, P.; Pineda, M.; Aguilar, M. Spectrophotometric Quantitation of Antioxidant Capacity through the Formation of a Phosphomolybdenum Complex: Specific Application to the Determination of Vitamin E. Anal. Biochem. 1999, 269, 337–341. [Google Scholar] [CrossRef]
- Balouiri, M.; Bouhdid, S.; Harki, E.H.; Sadiki, M.; Ouedrhiri, W.; Ibnsouda, S.K. Antifungal Activity of Bacillus spp. Isolated from Calotropis procera Ait. Rhizosphere against Candida Albicans. Asian J. Pharm. Clin. Res. 2015, 8, 213–217. [Google Scholar]
- El Barnossi, A.; Moussaid, F.; Iraqi Housseini, A. Antifungal Activity of Bacillussp. Gn-A11-18isolated from Decomposing Solid Green Household Waste in Water and Soil against Candida Albicans and Aspergillus Niger. E3S Web Conf. 2020, 150, 02003. [Google Scholar] [CrossRef]
- Balouiri, M.; Sadiki, M.; Ibnsouda, S.K. Methods for in vitro Evaluating Antimicrobial Activity: A Review. J. Pharm. Anal. 2016, 6, 71–79. [Google Scholar] [CrossRef] [PubMed]
- Eloff, J.N. A Sensitive and Quick Microplate Method to Determine the Minimal Inhibitory Concentration of Plant Extracts for Bacteria. Planta Med. 1998, 64, 711–713. [Google Scholar] [CrossRef]
- Chebaibi, A.; Marouf, Z.; Rhazi-Filali, F.; Fahim, M.; Ed-Dra, A. Evaluation of Antimicrobial Activity of Essential Oils from Seven Moroccan Medicinal Plants. Phytotherapie 2016, 14, 355–362. [Google Scholar] [CrossRef]
- Heidari, M.; Bahramsoltani, R.; Abdolghaffari, A.H.; Rahimi, R.; Esfandyari, M.; Baeeri, M.; Hassanzadeh, G.; Abdollahi, M.; Farzaei, M.H. Efficacy of Topical Application of Standardized Extract of Tragopogon Graminifolius in the Healing Process of Experimental Burn Wounds. J. Tradit. Complement. Med. 2019, 9, 54–59. [Google Scholar] [CrossRef]
- Winter, C.A.; Risley, E.A.; Nuss, G.W. Carrageenin-Induced Edema in Hind Paw of the Rat as an Assay for Antiinflammatory Drugs. Proc. Soc. Exp. Biol. Med. 1962, 111, 544–547. [Google Scholar] [CrossRef] [PubMed]
- Bentley, G.A.; Newton, S.H.; Starr, J. Evidence for an action of morphine and the enkephalins on sensory nerve endings in the mouse peritoneum. Pharmacology 1981, 73, 325–332. [Google Scholar] [CrossRef] [PubMed]
- Chlif, N.; Diouri, M.; El Messaoudi, N.; Ed-Dra, A.; Filali, F.R.; Bentayeb, A. Phytochemical Composition, Antioxidant and Antibacterial Activities of Extracts from Different Parts of Brocchia cinerea (Vis.). Biointerface Res. Appl. Chem. 2022, 12, 4432–4447. [Google Scholar] [CrossRef]
- Ben moussa, M.T.; Cherif, R.A.; Lekhal, S.; Bounab, A.; Youcef, H. Dosage Des Composés Phénoliques et Détermination de l’activité Antioxydante Des Extraits Méthanoliques de Brocchia cinerea VIS del’ Algérie (Sud-Est). Alger. J. Pharm. 2022, 4, 49–59. [Google Scholar]
- Belyagoubi-Benhammou, N.; Belyagoubi, L.; Bekkara, F.A. Phenolic Contents and Antioxidant Activities in vitro of Some Selected Algerian Plants. J. Med. Plants Res. 2014, 8, 1198–1207. [Google Scholar] [CrossRef]
- Bouziane, M.; Badjah-Hadj-Ahmed, Y.; Hadj-Mahammed, M. Chemical Composition of the Essential Oil of Brocchia cinerea Grown in South Eastern of Algeria. Asian J. Chem. 2013, 25, 3917–3921. [Google Scholar] [CrossRef]
- Dendougui, H.; Seghir, S.; Jay, M.; Benayache, F.; Benayache, S. Flavonoids from Cotula cinerea Del. Int. J. Med. Aromat. Plant 2012, 2, 2249–4340. [Google Scholar]
- Arabsalehi, F.; Rahimmalek, M.; Sabzalian, M.R.; Ghanadian, M.; Matkowski, A.; Szumny, A. Changes in Polyphenolic Composition, Physiological Characteristics, and Yield-Related Traits of Moshgak (Ducrosia anethifolia Boiss.) Populations in Response to Drought Stress. Protoplasma 2022, 1–19. [Google Scholar] [CrossRef] [PubMed]
- Mirniyam, G.; Rahimmalek, M.; Arzani, A.; Matkowski, A.; Gharibi, S.; Szumny, A. Changes in Essential Oil Composition, Polyphenolic Compounds and Antioxidant Capacity of Ajowan (Trachyspermum ammi L.) Populations in Response to Water Deficit. Foods 2022, 11, 3084. [Google Scholar] [CrossRef]
- Gharibi, S.; Sayed Tabatabaei, B.E.; Saeidi, G.; Talebi, M.; Matkowski, A. The Effect of Drought Stress on Polyphenolic Compounds and Expression of Flavonoid Biosynthesis Related Genes in Achillea pachycephala Rech.F. Phytochemistry 2019, 162, 90–98. [Google Scholar] [CrossRef]
- Khallouki, F.; Sellam, K.; Koyun, R.; Ricarte, I.; Alem, C.; Elrhaffari, L.; Owen, R.W. Phytoconstituents and in vitro Evaluation of Antioxidant Capacities of Cotula cinerea (Morocco) Methanol Extracts. Rec. Nat. Prod. 2015, 9, 572–575. [Google Scholar]
- Kasrati, A.; Alaoui Jamali, C.; Bekkouche, K.; Wohlmuth, H.; Leach, D.; Abbad, A. Comparative Evaluation of Antioxidant and Insecticidal Properties of Essential Oils from Five Moroccan Aromatic Herbs. J. Food Sci. Technol. 2015, 52, 2312–2319. [Google Scholar] [CrossRef]
- Teodoro, G.; Ellepola, K.; Seneviratne, C.; Koga-ito, C. Potential Use of Phenolic Acids as Anti-Candida Agents: A Review. Front. Microbiol. 2015, 6, 1420. [Google Scholar] [CrossRef]
- Ekambaram, S.P.; Perumal, S.S.; Balakrishnan, A.; Marappan, N.; Gajendran, S.S.; Viswanathan, V. Antibacterial Synergy between Rosmarinic Acid and Antibiotics against Methicillin-Resistant Staphylococcus aureus. J. Intercult. Ethnopharmacol. 2016, 5, 358. [Google Scholar] [CrossRef]
- Campos, F.M.; Couto, J.A.; Hogg, T.A. Influence of Phenolic Acids on Growth and Inactivation of Oenococcus oeni and Lactobacillus hilgardii. J. Appl. Microbiol. 2000, 94, 167–174. [Google Scholar] [CrossRef]
- Wu, D.; Kong, Y.; Han, C.; Chen, J.; Hu, L.; Jiang, H.; Shen, X. D-Alanine: D-Alanine Ligase as a New Target for the Flavonoids Quercetin and Apigenin. Int. J. Antimicrob. Agents 2008, 32, 421–426. [Google Scholar] [CrossRef] [PubMed]
- Ferreira, C.; Saavedra, M.J.; Simo, M. Antibacterial Activity and Mode of Action of Ferulic. Microb. Drug Resist. 2013, 19, 256–265. [Google Scholar] [CrossRef]
- Mssillou, I.; Bakour, M.; Slighoua, M.; Laaroussi, H.; Saghrouchni, H.; Amrati, F.E.-Z.; Lyoussi, B.; Derwich, E. Investigation on Wound Healing Effect of Mediterranean Medicinal Plants and Some Related Phenolic Compounds: A Review. J. Ethnopharmacol. 2022, 298, 115663. [Google Scholar] [CrossRef]
- Jawhari, F.Z.; El Moussaoui, A.; Bourhia, M.; Imtara, H.; Mechchate, H.; Es-Safi, I.; Ullah, R.; Ezzeldin, E.; Mostafa, G.A.; Grafov, A.; et al. Anacyclus pyrethrum (L): Chemical Composition, Analgesic, Anti-Inflammatory, and Wound Healing Properties. Molecules 2020, 25, 5469. [Google Scholar] [CrossRef]
- Ghouti, D.; Rached, W.; Abdallah, M.; Pires, T.C.S.P.; Calhelha, R.C.; Alves, M.J.; Abderrahmane, L.H.; Barros, L.; Ferreira, I.C.F.R. Phenolic Profile and in vitro Bioactive Potential of Saharan Juniperus phoenicea L. and Cotula cinerea (Del) Growing in Algeria. Food Funct. 2018, 9, 4664–4672. [Google Scholar] [CrossRef]
- Tian, C.; Liu, X.; Chang, Y.; Wang, R.; Lv, T.; Cui, C.; Liu, M. Investigation of the Anti-Inflammatory and Antioxidant Activities of Luteolin, Kaempferol, Apigenin and Quercetin. S. Afr. J. Bot. 2021, 137, 257–264. [Google Scholar] [CrossRef]
- Peng, W.; Han, P.; Yu, L.; Chen, Y.; Ye, B.; Qin, L.; Xin, H.; Han, T. Anti-Allergic Rhinitis Effects of Caffeoylquinic Acids from the Fruits of Xanthium strumarium in Rodent Animals via Alleviating Allergic and Inflammatory Reactions. Rev. Bras. Farmacogn. 2019, 29, 46–53. [Google Scholar] [CrossRef]
- Kang, J.Y.; Khan, M.N.A.; Park, N.H.; Cho, J.Y.; Lee, M.C.; Fujii, H.; Hong, Y.K. Antipyretic, Analgesic, and Anti-Inflammatory Activities of the Seaweed Sargassum fulvellum and Sargassum thunbergii in Mice. J. Ethnopharmacol. 2008, 116, 187–190. [Google Scholar] [CrossRef]

| TPC: mg GAE/g of Extract | Fl: mg QE/g of Extract | CT: mg TAE/g of Extract | |
|---|---|---|---|
| BCAE | 13.09 ± 0.13 | 9.86 ± 0.41 | 17.07 ± 0.36 |
| BCEE | 21.06 ± 0.04 | 10.43 ± 0.13 | 24.05 ± 0.24 |
| Phenolic Compounds | RT (min) | DO (nm) |
|---|---|---|
| Gallic acid | 4.69 | 280 |
| Caffeic acid | 7.777 | 300 |
| Rosmarinic acid | 8.300 | 320 |
| Quercetin | 9.403 | 370 |
| TAC (mg AAE/g Extract) | FRAP (EC50 mg/mL) | DPPH (IC50 mg/mL) | |||||
|---|---|---|---|---|---|---|---|
| BCEE | BCAE | BCEE | BCAE | Quercitin | BCEE | BCAE | Quercitin |
| 5.312 ± 0.217 | 2.832 ± 0.148 | 0.248668 | - | 0.007295 | 0.144 | 0.049 | 0.000799 |
| Zone of Inhibition (mm) | CMI mg/mL | |||||
|---|---|---|---|---|---|---|
| P. aeruginosa | E. coli | B.subtils | P. aeruginosa | E. coli | B.subtils | |
| BCEE | - | - | 23.16 ± 0.76 | - | - | 10 ± 0.0 |
| BCAE | 18.66 ± 1.6 | - | - | 10 ± 0.0 | - | - |
Disclaimer/Publisher’s Note: The statements, opinions and data contained in all publications are solely those of the individual author(s) and contributor(s) and not of MDPI and/or the editor(s). MDPI and/or the editor(s) disclaim responsibility for any injury to people or property resulting from any ideas, methods, instructions or products referred to in the content. |
© 2023 by the authors. Licensee MDPI, Basel, Switzerland. This article is an open access article distributed under the terms and conditions of the Creative Commons Attribution (CC BY) license (https://creativecommons.org/licenses/by/4.0/).
Share and Cite
Agour, A.; Mssillou, I.; El Barnossi, A.; Chebaibi, M.; Bari, A.; Abudawood, M.; Al-Sheikh, Y.A.; Bourhia, M.; Giesy, J.P.; Aboul-Soud, M.A.M.; et al. Extracts of Brocchia cinerea (Delile) Vis Exhibit In Vivo Wound Healing, Anti-Inflammatory and Analgesic Activities, and Other In Vitro Therapeutic Effects. Life 2023, 13, 776. https://doi.org/10.3390/life13030776
Agour A, Mssillou I, El Barnossi A, Chebaibi M, Bari A, Abudawood M, Al-Sheikh YA, Bourhia M, Giesy JP, Aboul-Soud MAM, et al. Extracts of Brocchia cinerea (Delile) Vis Exhibit In Vivo Wound Healing, Anti-Inflammatory and Analgesic Activities, and Other In Vitro Therapeutic Effects. Life. 2023; 13(3):776. https://doi.org/10.3390/life13030776
Chicago/Turabian StyleAgour, Abdelkrim, Ibrahim Mssillou, Azeddin El Barnossi, Mohamed Chebaibi, Amina Bari, Manal Abudawood, Yazeed A. Al-Sheikh, Mohammed Bourhia, John P. Giesy, Mourad A. M. Aboul-Soud, and et al. 2023. "Extracts of Brocchia cinerea (Delile) Vis Exhibit In Vivo Wound Healing, Anti-Inflammatory and Analgesic Activities, and Other In Vitro Therapeutic Effects" Life 13, no. 3: 776. https://doi.org/10.3390/life13030776
APA StyleAgour, A., Mssillou, I., El Barnossi, A., Chebaibi, M., Bari, A., Abudawood, M., Al-Sheikh, Y. A., Bourhia, M., Giesy, J. P., Aboul-Soud, M. A. M., Lyoussi, B., & Derwich, E. (2023). Extracts of Brocchia cinerea (Delile) Vis Exhibit In Vivo Wound Healing, Anti-Inflammatory and Analgesic Activities, and Other In Vitro Therapeutic Effects. Life, 13(3), 776. https://doi.org/10.3390/life13030776

